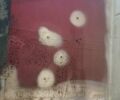
Красный Даф XF 95, объемом двигателя 12.58 л и пробегом 789 тыс. км за 18000 $, фото 58 на Automoto.ua

Daf XF 95, 2006 г.в.
Информация от владельца
| Объявление от | Владелец |
| Коробка передач | Ручная / Механика |
| Тип топлива | Дизель |
| Двигатель | 12.58 л |
| Привод | Задний |
| Тип кузова | Фургон |
| Цвет | Красный |
| Мест в салоне | 2 |
| Количество дверей | 2 |
| Дата публикации | 08.11.2025 |
Основная информация
по VIN коду
Полная информация по VIN коду
-
Отчет о скрытых повреждениях
-
Модифицированный пробег
-
Фотографии истории автомобиля
-
История обслуживания
-
Несколько владельцев
-
Записи о краже
-
Частые неисправности
-
Другая полезная информация
Комментарий продавца
Комплектация
Мультимедиа |
|
Экстерьер |
|
Более выгодно
С этим авто также ищут
Купить б/у Daf XF 95, 2006
При оформлении лизинга вы получаете сразу автомобиль. Лизинг предполагает полный спектр услуг: покупка, страхование, техническое и юридическое обслуживание. Приобретение машины в кредит - это деньги в займ под процент.
Все дополнительные расходы (регистрация, страховки, налоги) в лизинге равномерно распределены между ежемесячными платежами. При покупке авто в кредит придется выделить деньги на все это сразу.
Чтобы получить авто в лизинг нужно:
- Паспорт
- Идентификационный код
- Водительское удостоверение.
- выбирать автомобиль в каталоге AutoMoto.ua и оставить заявку,
- пообщаться с менеджером и узнать лучшие условия от банков для оформления кредита,
- подать пакет необходимых документов,
- дождаться решения,
- при условии положительного решения - подписать кредитный договор и получить деньги.
Для оформления автокредита необходимы:
- паспорт,
- идентификационный код,
- Кредитный договор с графиком платежей
- Паспорт потребительского кредита (1 страница)
- Свидетельство о регистрации транспортного средства (оригинал). В случае отсутствия физического экземпляра свидетельства, разрешается использовать скриншоты Свидетельства о регистрации транспортного средства из приложения «Дія», при условии обязательного наличия на них всех реквизитов, необходимых для выполнения проверок согласно данному Порядку.
- Оригинал паспорта гражданина Украины (оригинал в виде книжечки или ID-карта)
Важно, чтобы дата выдачи свидетельства о регистрации ТС была не ранее даты оформления кредитного договора, и ФИО в свидетельстве о регистрации транспортного средства - должно совпадать с ФИО Заемщика.